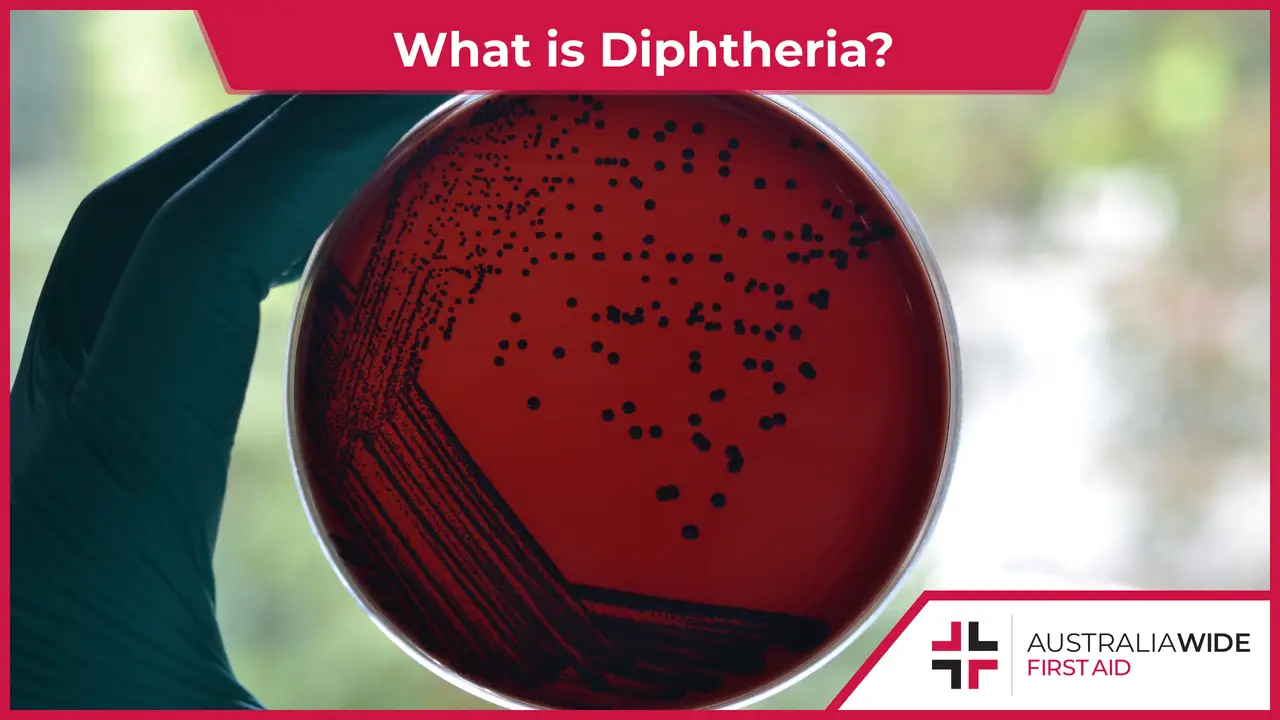
diphtheria-symptoms-and-causes

Diphtheria: Symptoms and Causes

Diphtheria is a bacterial infection caused by the bacterium Corynebacterium diphtheria that affects the upper airways and the skin. The bacteria produces a thick membrane in the throat that obstructs breathing and can result in complications such as heart failure and kidney failure, even leading to death.
Northern New South Wales recently confirmed a second case of diphtheria. Both victims were children aged two and six respectively and both children were unvaccinated against diphtheria. Diphtheria is a bacterial infection, which if left untreated can become potentially fatal. Today, we are going to take a closer look at what is diphtheria, the symptoms of diphtheria, how it spreads from one person to another, its complications and how it can be avoided and treated.
It is a bacterial infection caused by the bacterium Corynebacterium diphtheria. The bacteria release a toxin that affects the nose, throat, tonsils and sometimes the skin. It produces a thick membrane in the throat, making breathing difficult or even completely obstructing the windpipe, leading to suffocation and death. The toxin produced by the bacteria can even cause life-threatening heart failure and paralysis.
According to the Australian Government Department of Health and Aged Care, the last reported case or death due to diphtheria was in 1992. It was viral and at its peak in 1921 and again in 1935, affecting 23,199 and 15,000 Australians respectively. Diphtheria cases dropped to nearly zero in Australia after introducing school based vaccination programs in the 1930s. Diphtheria infection has been rare in Australia since the widespread use of the effective vaccines. In 2017, 94% of Australians 5 year olds were fully vaccinated against diphtheria.
The signs and symptoms include:

Diphtheria is spread by:
If you have diphtheria, you can stop the spread of this bacterial infection by:
Without treatment or vaccination, the complications of diphtheria are extremely fatal and life threatening.
They include:

The best protection against diphtheria is vaccination. The diphtheria vaccine was developed in the early 1920s and was used nationwide in Australia starting with schools in 1932. In Australia, the vaccines for diphtheria are available only in combination with tetanus.
It may also include other antigens such as pertussis, inactivated poliovirus, hepatitis B and Haemophilus influenzae type B. The Australian Government Department of Health’s Immunisation Handbook recommends diphtheria-containing vaccines for children at 2, 4, 6 and 18 months, children 4 years of age and adolescents at 11 to 13 years of age.
Travellers are recommended to get vaccinated every 10 years. The diphtheria-containing vaccines are given as an intramuscular injection, which is an injection into the muscles. The injection sites are commonly the muscles of the upper arm (deltoid muscle) or the upper outer thigh (vastus lateralis muscle).
The major risk factor of diphtheria is being unvaccinated. Since diphtheria cases have been rare and unheard of, the global vaccination rate of diphtheria has declined steadily. With more people remaining unvaccinated due to lack of knowledge, that is one reason for the reemergence of diphtheria cases.
Another reason would be travelling to countries where diphtheria is prevalent. Such destinations include Southeast Asia, Papua New Guinea and eastern European countries. It is possible for fully vaccinated people to spread the bacteria to unvaccinated people since vaccination prevents the infection to the host body and be asymptomatic to the bacteria they carry at the back of their throat. Thus, they may still spread to unvaccinated people who might suffer the symptoms and complications.
Protect yourself and your children by getting the diphtheria vaccine at the community health clinics or public hospitals. Find an immunisation provider near you here. To learn to identify, prevent and manage the symptoms of diphtheria, book a date to learn First Aid with Australia Wide First Aid today!

May 1, 2025
Pterygium, also known as surfer's eye, is an ocular surface disease characterised by a growth of limbal and conjunctival tissue over the cornea. Fortunately, you can practice many eye health habits to help prevent the development of pterygium and other risks.

April 3, 2025
Tuberculosis is a severe bacterial infection that mainly affects the lungs and other parts of the body, including the nervous system. This contagious disease can quickly spread in crowded areas when an infected person coughs, talks, or sneezes.

February 13, 2025
Melioidosis is a bacterial infection caused by Burkholderia pseudomallei, a microorganism found in soil and water. This infection is often underdiagnosed due to symptoms mimicking many other illnesses. As such, awareness is critical for those living or working in affected regions.